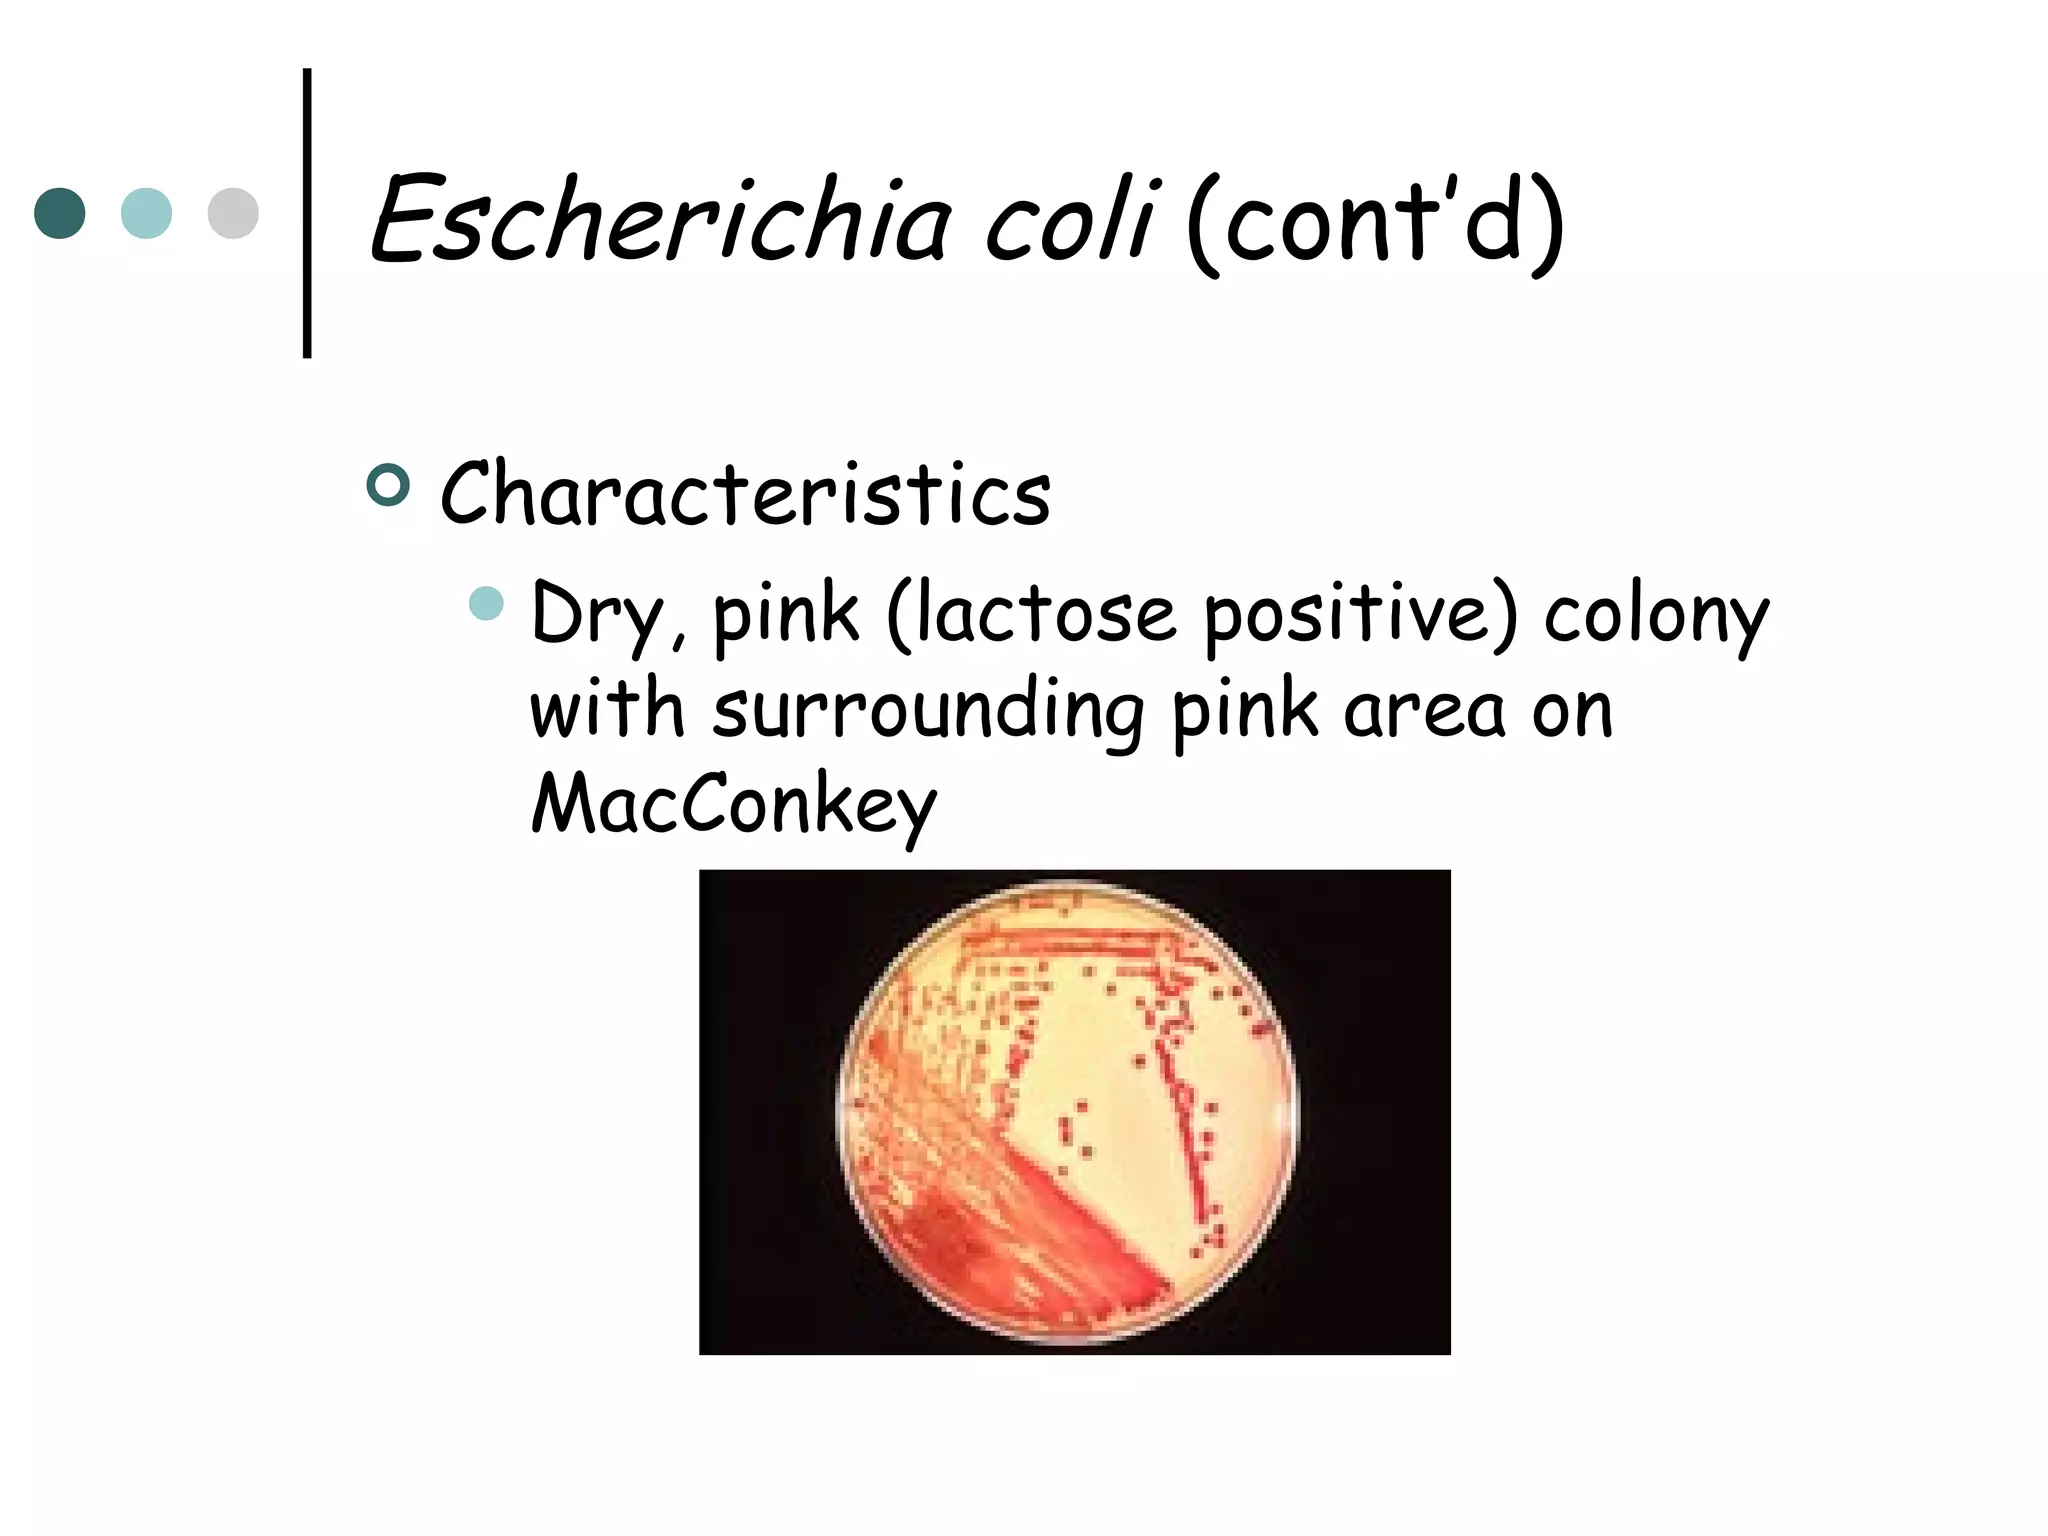
Escherichia coli (cont’d)


Characteristics
 Dry,

pink (lactose positive) colony
with surrounding pink area on
MacConkey
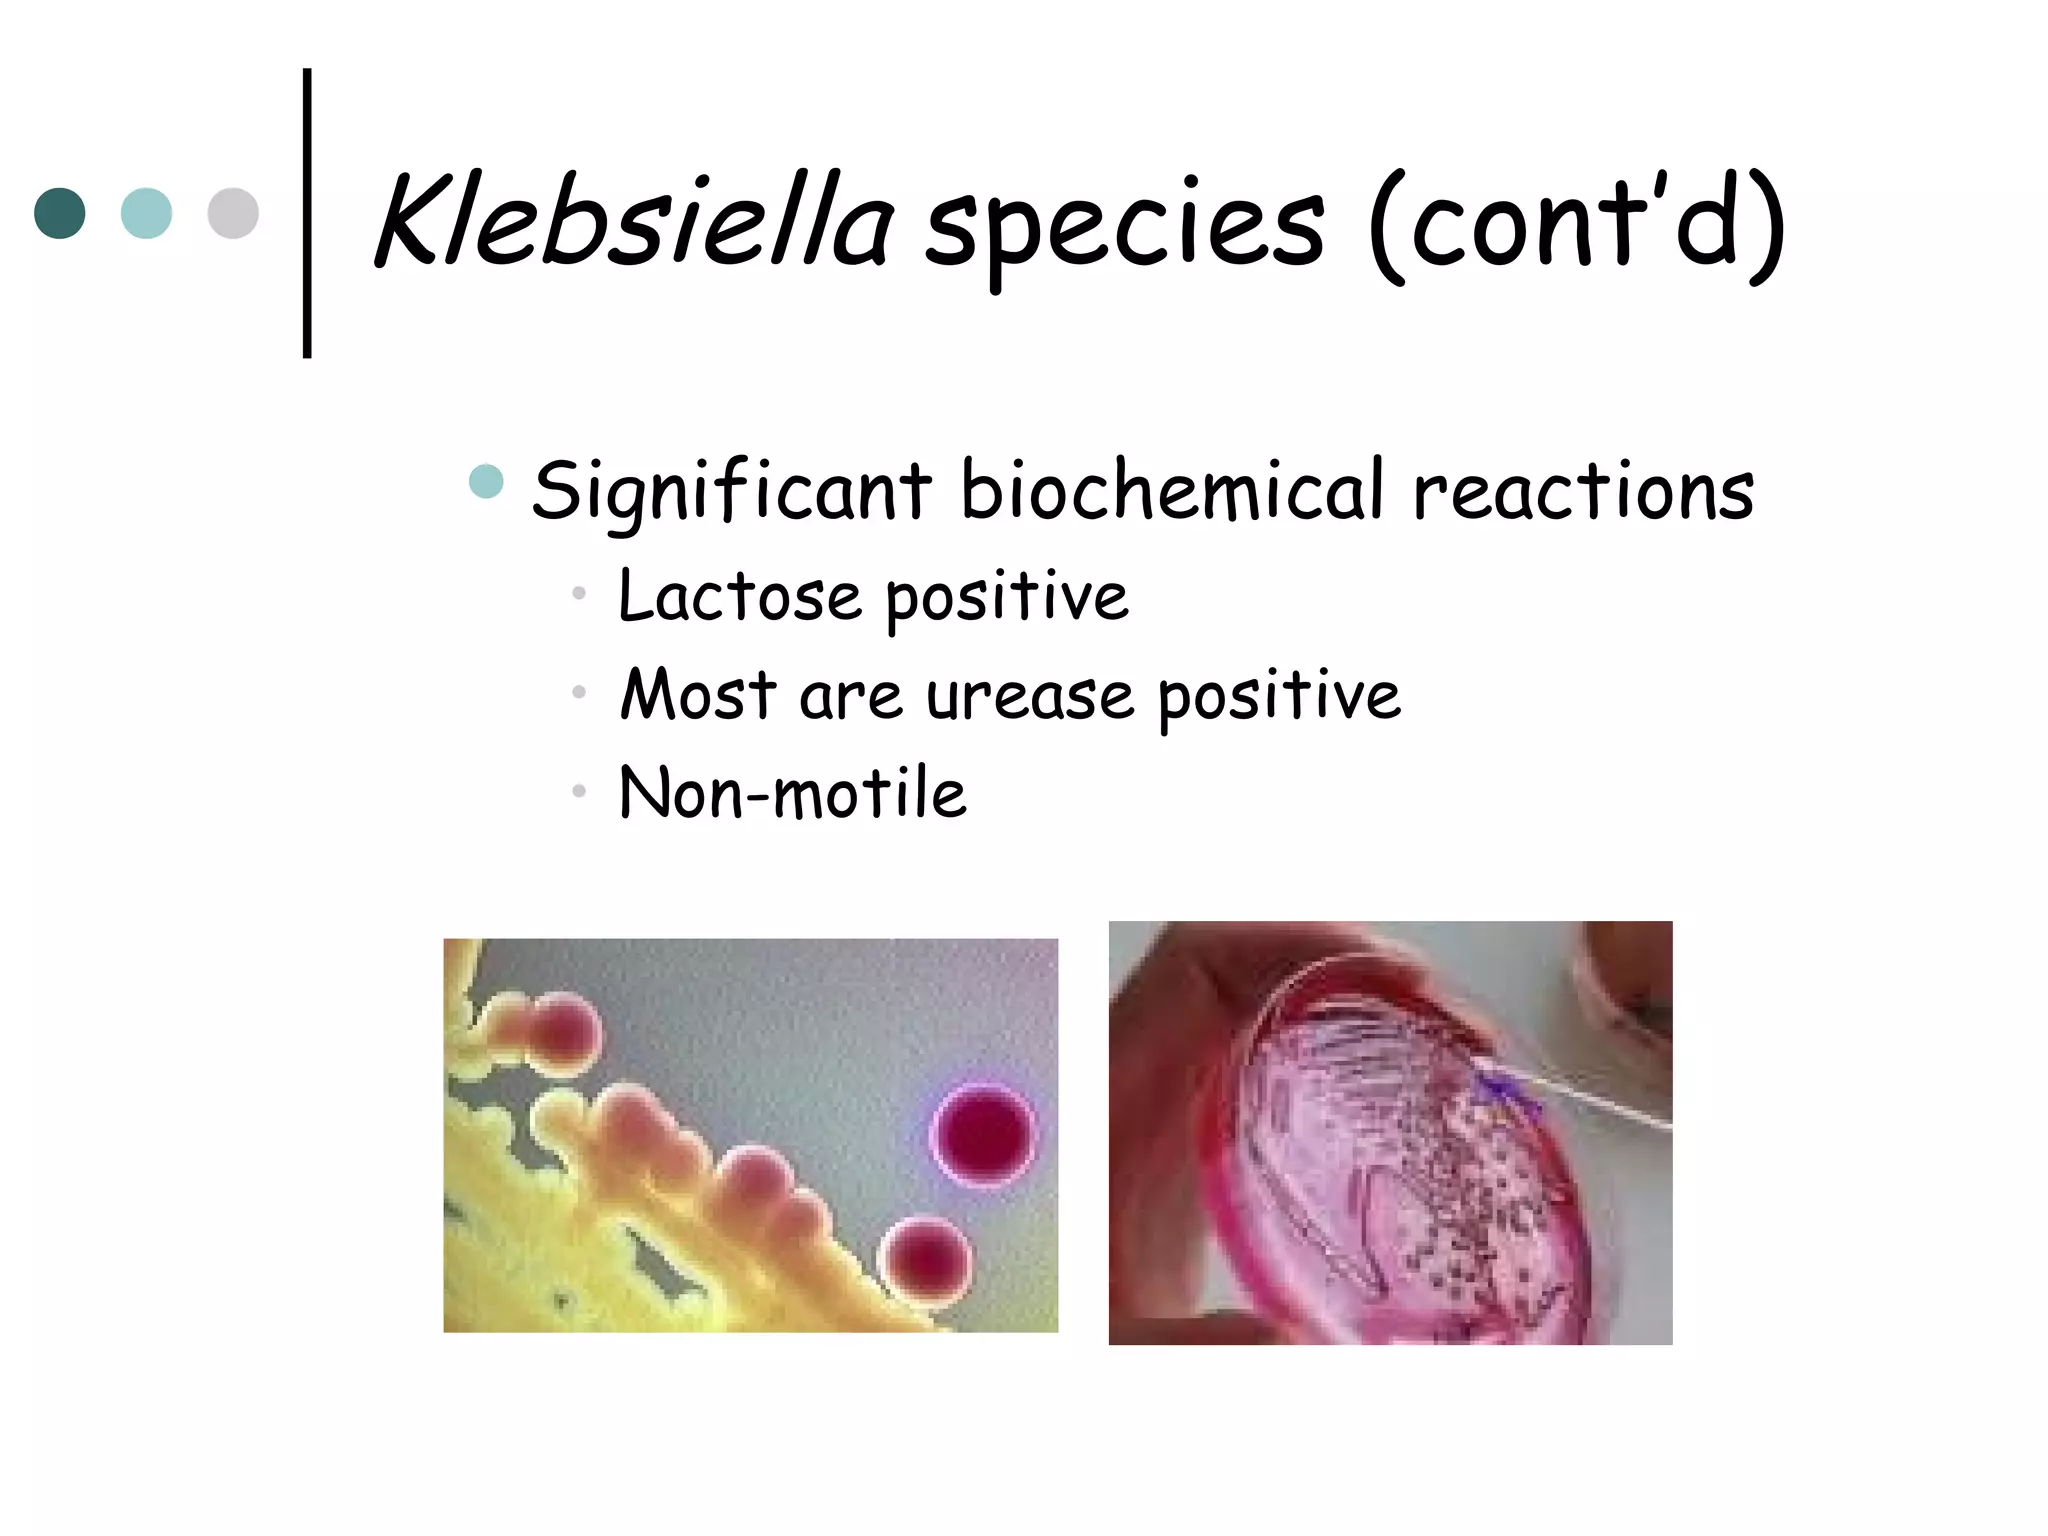
Klebsiella species (cont’d)
 Significant

biochemical reactions

• Lactose positive
• Most are urease positive
• Non-motile
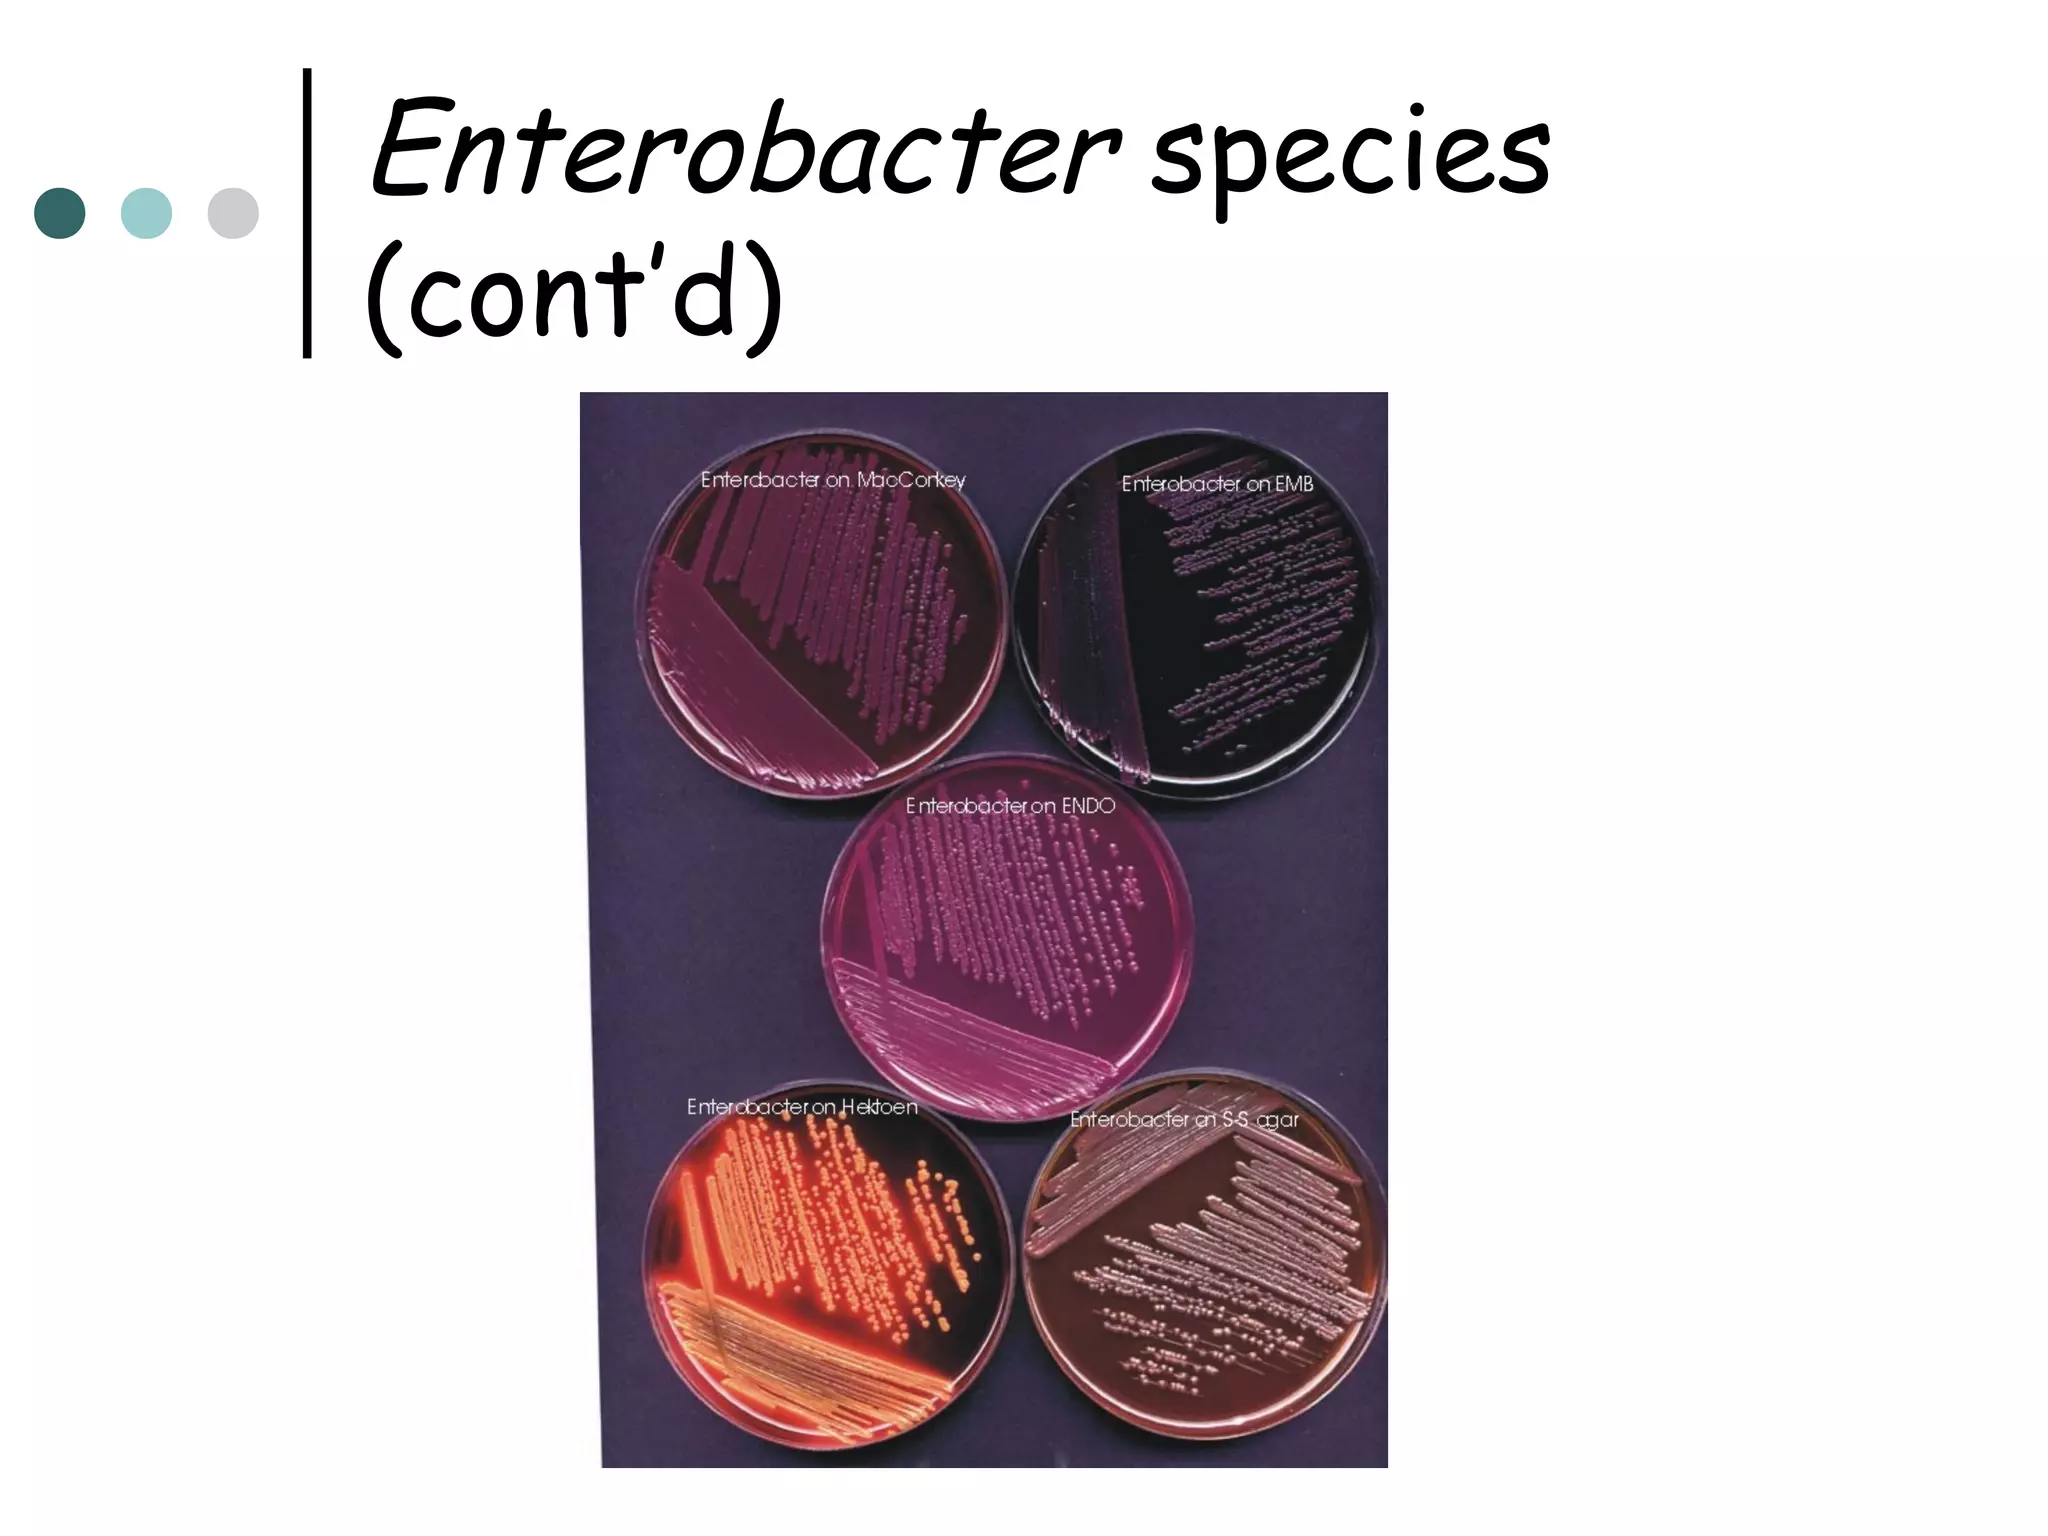
Enterobacter species
(cont’d)
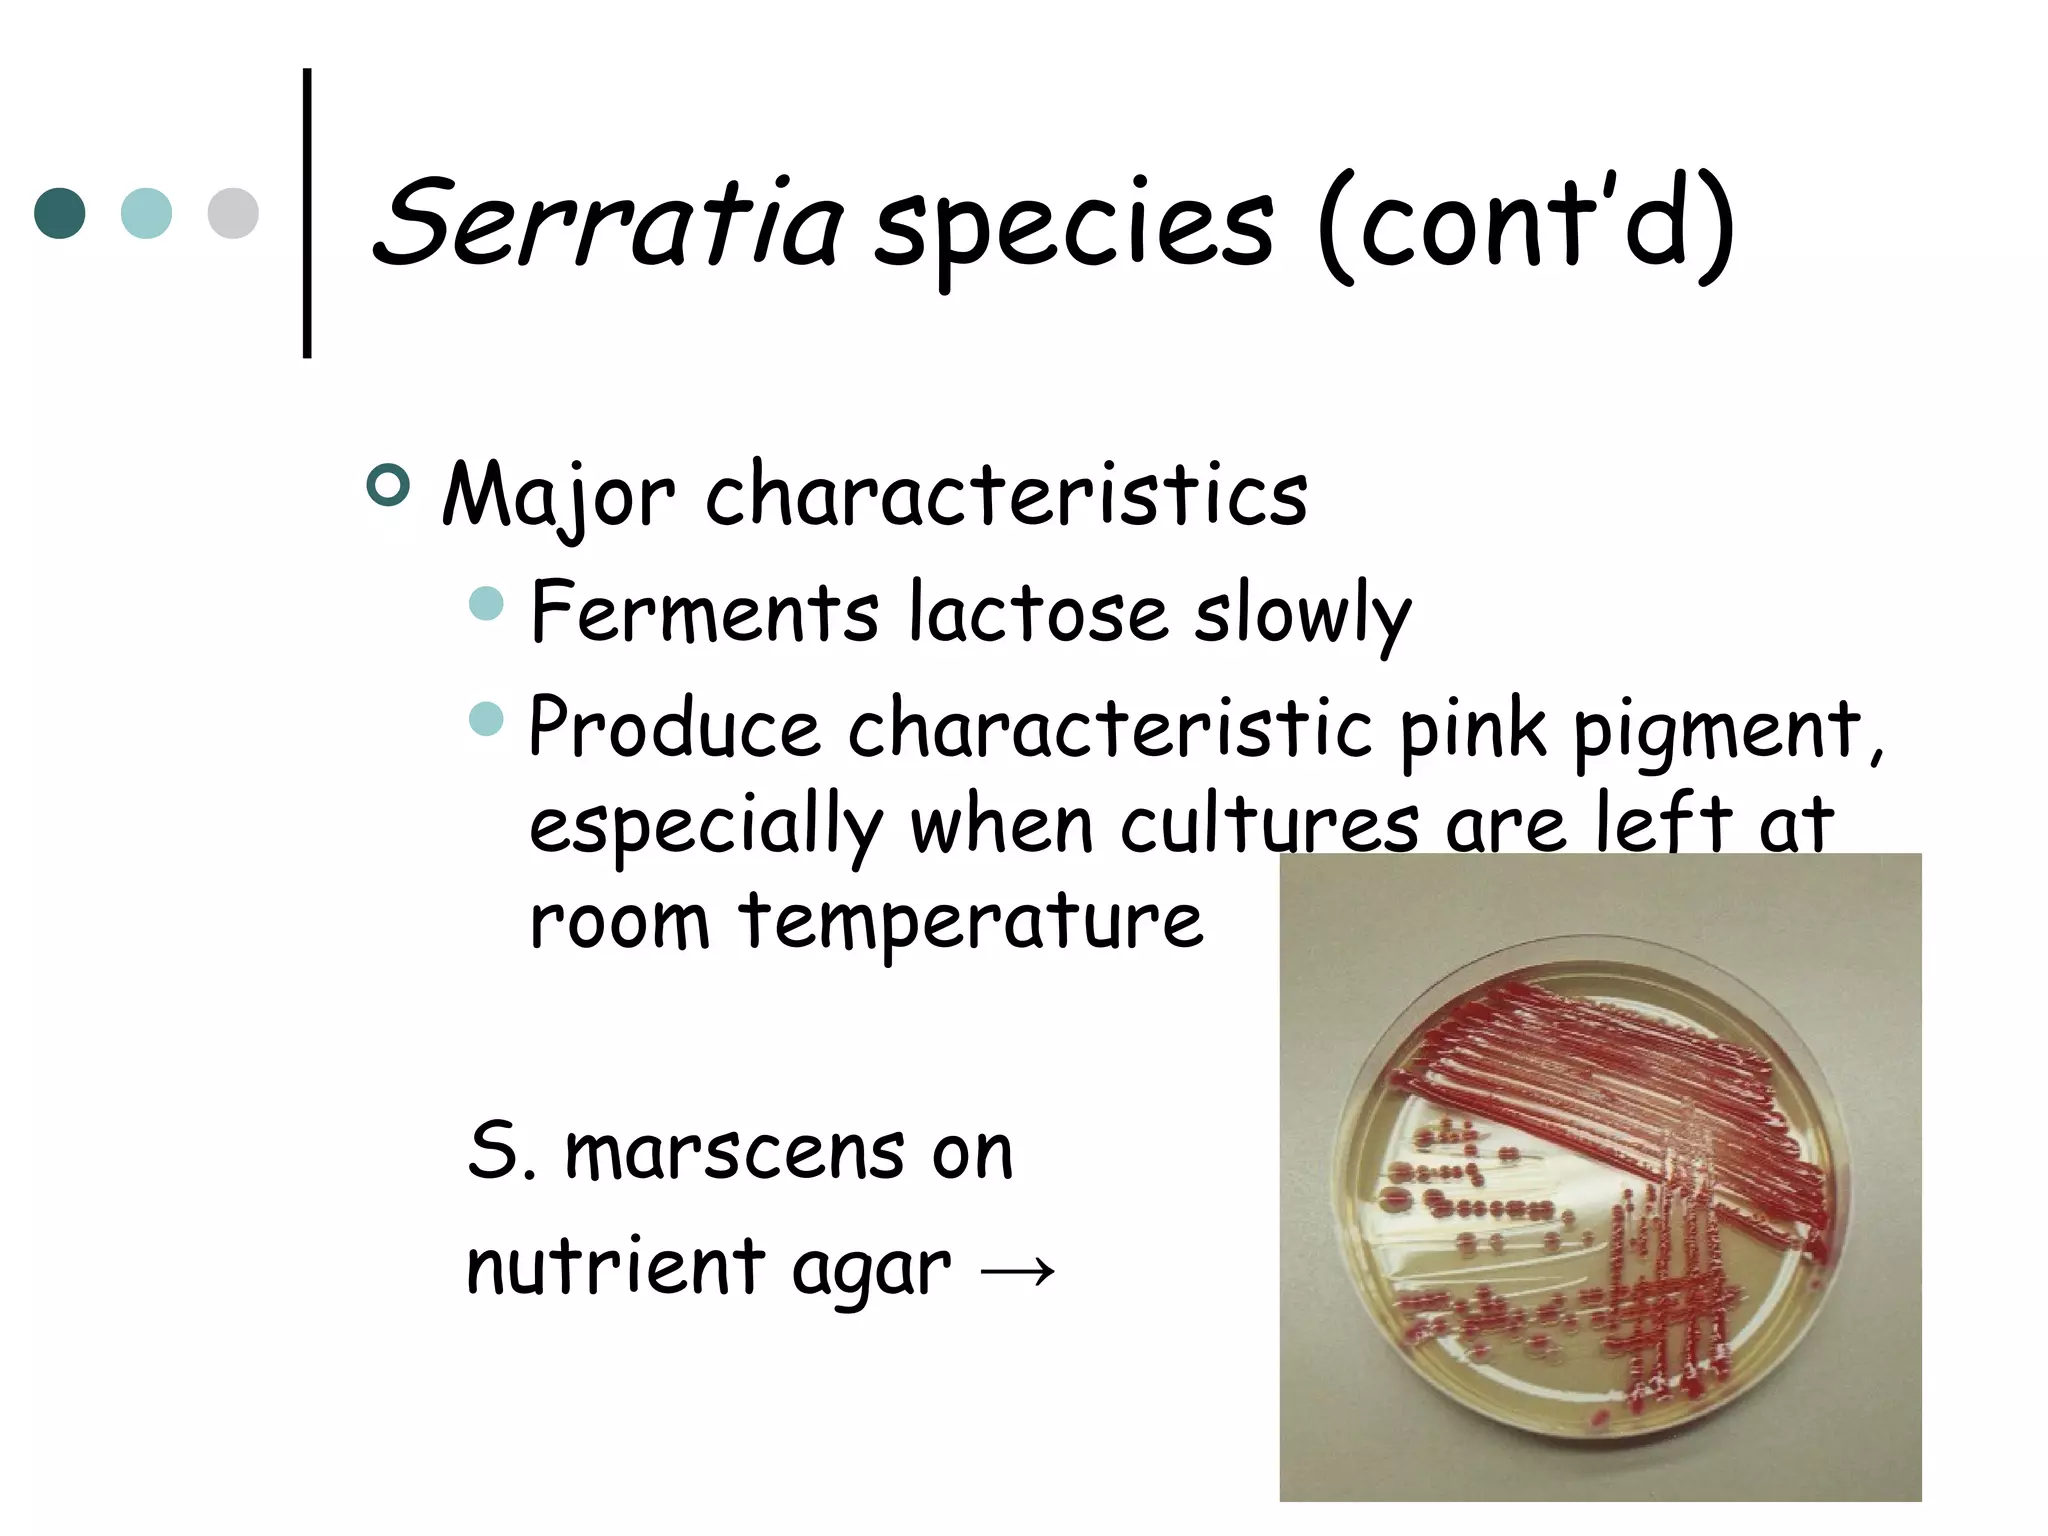
Serratia species (cont’d)


Major characteristics
 Ferments

lactose slowly
 Produce characteristic pink pigment,
especially when cultures are left at
room temperature
S. marscens on
nutrient agar →
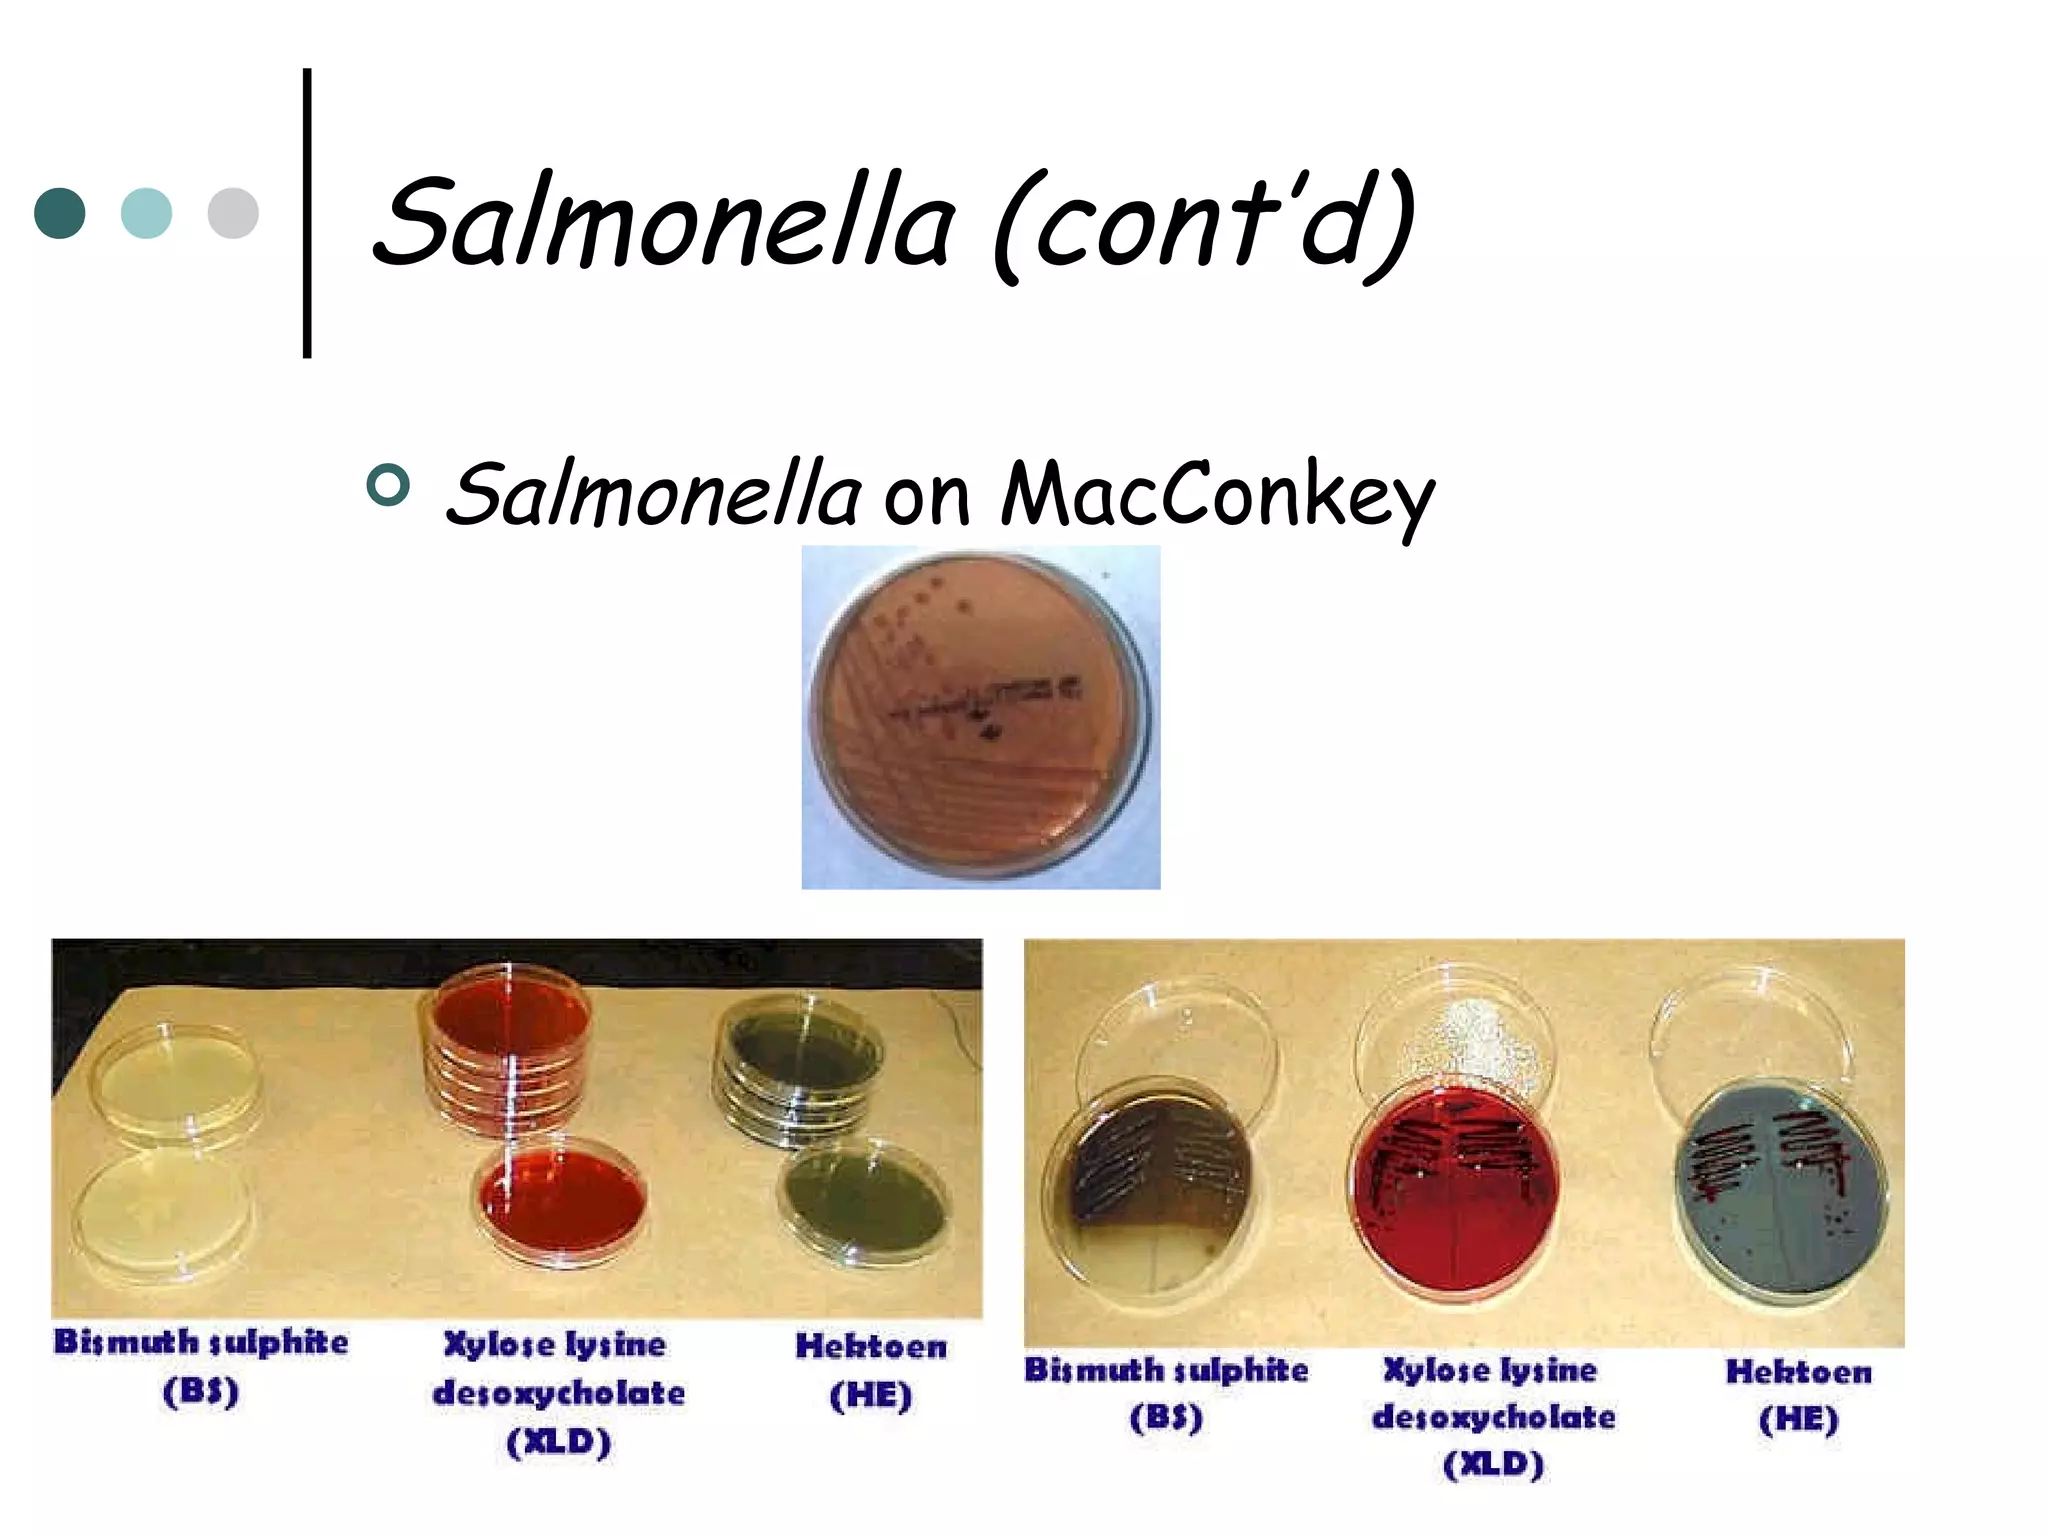
Salmonella (cont’d)


Salmonella on MacConkey
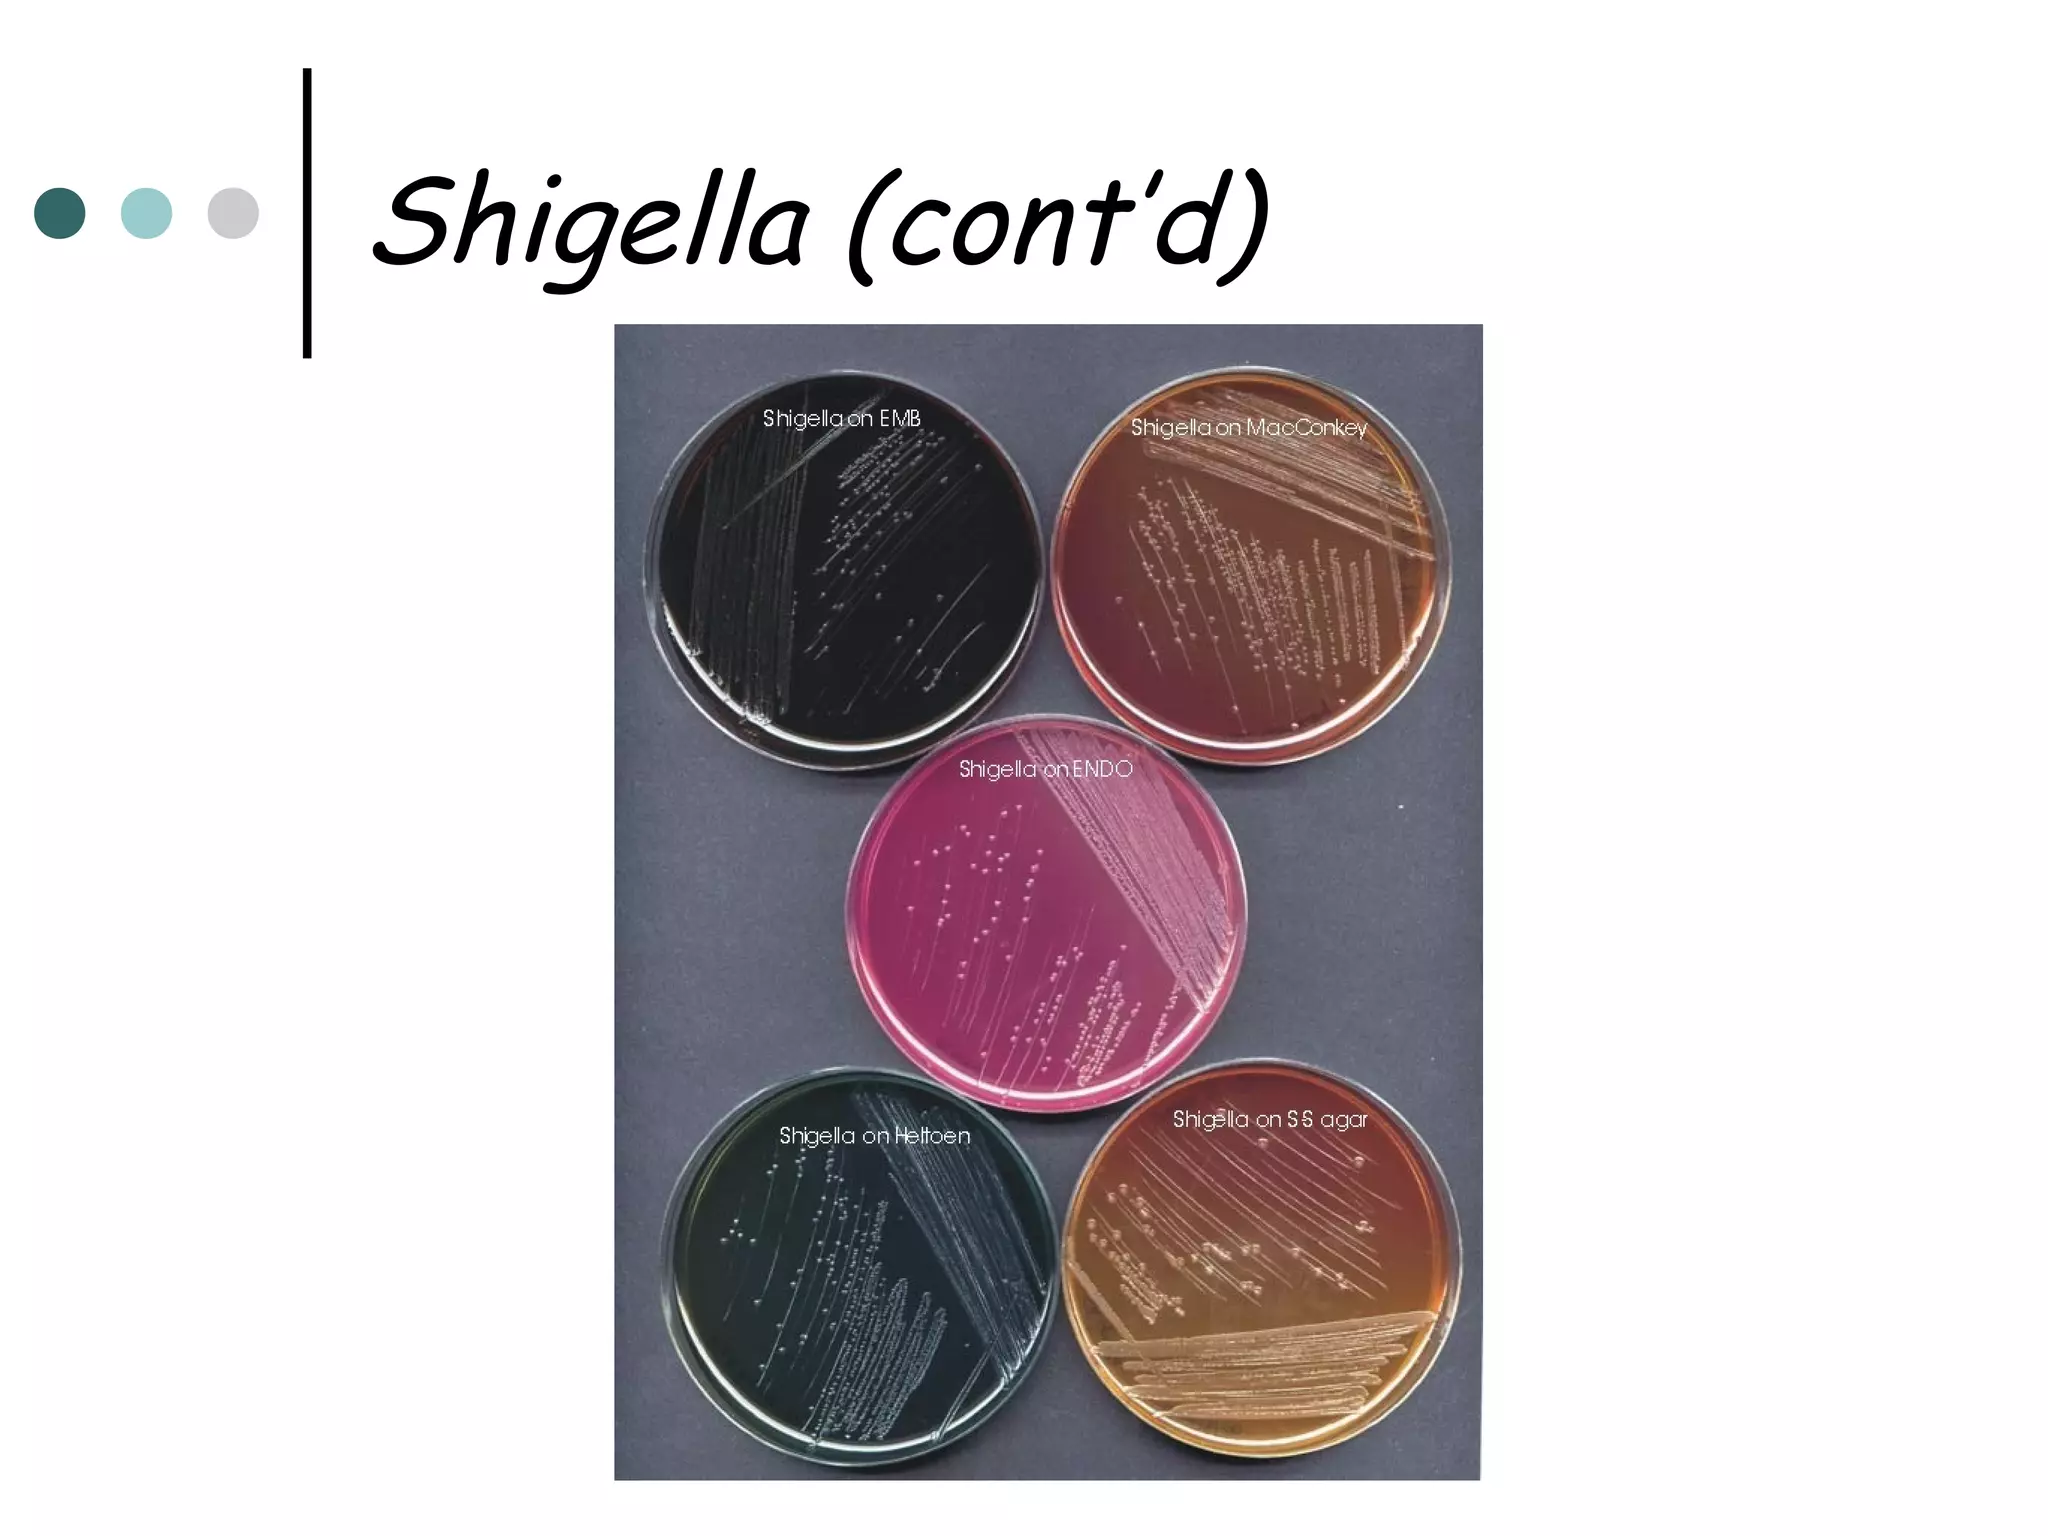
Shigella (cont’d)

This document provides an overview of the Enterobacteriaceae family of bacteria, including their classification, characteristics, clinical significance, and important pathogenic species such as Escherichia coli, Klebsiella, Salmonella, Shigella, and Yersinia. Key features of Enterobacteriaceae include being Gram-negative, non-spore forming bacilli that are oxidase-negative, reduce nitrates to nitrites, and ferment glucose. They can cause a variety of opportunistic infections and some are primary intestinal pathogens. The document describes the microbiological properties and diseases associated with major pathogenic genera.